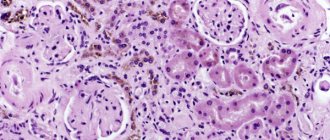

Что такое глиоз головного мозга
Естественный процесс замещения погибших нейронов, имеющий защитный характер, носит название – глиоз белого вещества головного мозга. В норме за 10 лет в здоровом организме разрушается около 4% всех нейроцитов, поэтому глиоз — это одно из проявлений старения.
При развитии патологических процессов, вызывающих гибель большого участка нервной ткани, глиоциты замещают отмершие импульсные клетки, хотя генерировать и проводить нервные импульсы они не могут. Благодаря этому распространение патологического процесса замедляется, а обмен веществ пораженного участка сохраняется в полном объеме.
Чем же обусловлено развитие глиоза тканей головного мозга, что это такое и в какой момент процесс становится опасным
ЦНС включает три разновидности клеток:
- Нейроны – основные функциональные клетки нервной системы, формирующие и передающие импульсы от головного мозга к эффекторам (исполнительным органам, обеспечивающим ответную реакцию на определенный раздражитель).
- Эпендимальные клеточные элементы, выстилающие желудочки головного мозга и центральный спинномозговой канал.
- Клетки глиозной ткани, обладающие опорными и защитными функциями. Они образуют рубец после гибели нейроцитов по различным причинам, в том числе и из-за демиелинизирующих заболеваний.
Глиальная ткань (нейроглия) располагается между функциональными элементами и является опорой для всех клеточных структур. В норме она защищает головной мозг от травм при резких движениях, а также от развития инфекционных процессов.
Составляя около 40% от объема всех тканей черепной коробки, глия создает условия для нормальной работы нервной системы. В критических ситуациях она формирует своеобразный рубец, который не дает остановиться процессам метаболизма и частично берет на себя задачи других клеток. Помимо этого нейроглия участвует в формировании новых нервных волокон, изолирующих очаг поражения и защищающих здоровые ткани.
Методы диагностики
Данную патологию легко перепутать с другими заболеваниями и травматическими изменениями. Очень важно точно установить причины, которые спровоцировали перерождение тканей мозга. Для этого сейчас широко применяются инструментальные методы:
- ЭЭГ. Поможет выявить нарушения в работе нейронов. Такое исследование назначают, если нарушена активность мозга. Диагностическая процедура обнаруживает патологическую судорожную активность, что способствует предотвращению новых припадков.
- Томография (КТ, МРТ). Визуально покажет состояние мозга, поможет определить объем и локализацию повреждений. При томографии можно легко выявить заболевания сосудистого генезиса. МРТ фиксирует нарушенный обмен веществ, рубцы, опухоли и т.д. При помощи МРТ можно диагностировать глиоз белого вещества в лобных долях. Другими методами этот процесс не выявить. Именно МРТ позволяет обнаружить перивентрикулярный глиоз, который поражает зоны около желудочков мозга. Также этот метод помогает диагностировать периферические и перифокальные поражения.
Эти методы позволяют выявить также источник, спровоцировавший патологические изменения.
Глиозные изменения лобных долей часто наблюдаются в пожилом возрасте. При этом нет сопутствующих патологий.
Симптомы
Клинические признаки нейроглиоза зависят от основного заболевания, явившегося причиной его развития. Единичные очаги небольшого размера не дают специфической симптоматики и обнаруживаются при проведении МРТ по поводу другого заболевания. Настороженность вызывают следующие симптомы:
- головные боли, которые развиваются без видимых причин, носят длительный характер, высокую интенсивность и не проходят после приема спазмолитиков;
- нестабильные показатели артериального давления (резкое снижение или повышение АД в течение короткого времени);
- периодически возникающее головокружение;
- повышенная утомляемость и падение работоспособности;
- возникающие изменения слухового и зрительного восприятия;
- расстройство памяти и внимания;
- возникновение двигательных нарушений (при больших очагах поражения вплоть до судорожных состояний).
Существует прямая зависимость клинических проявлений от места локализации очага глиоза
- Супратенториальный глиоз проявляется в основном зрительными расстройствами – искажение размеров, формы и очертаний предметов, галлюцинации, выпадение зрительных полей, невозможность узнать предмет по внешнему виду.
- Поражение височных долей характеризуется длительными и частыми головными болями. Если поражение носит сосудистый характер, то к болевому синдрому присоединяются резкие перепады показателей артериального давления.
- Глиозные изменения белого вещества могут вызвать головокружение, повышение судорожной активности и развитие эпилептических припадков. Чаще такая симптоматика развивается в результате черепно-мозговых травм или как осложнение оперативного вмешательства.
- Локализация поражения в лобных долях в большинстве случаев является возрастным изменением. Если не было заболеваний, способных активизировать размножение глиальных клеток, процесс относится к первичной патологии:
- развивающейся у пожилых людей
- проявляющейся нарушением памяти и внимания, замедлением реакций, неточностью мелкой моторики.
При отсутствии адекватного лечения основного заболевания глиозные поражения увеличиваются в размерах. Это приводит к прогрессированию клинических проявлений и развитию осложнений.
Причины
Глиоз белого вещества развивается в результате ишемии, физического повреждения, воспаления. Среди возможных виновников расстройства:
- Менингит. Инфекционное поражение тканей.
- Энцефалит. Еще один вариант, только возбудитель совсем другой. Но результаты примерно идентичные. Без лечения — выраженная дегенерация и инвалидность. А возможно и гибель от осложнений.
- Интоксикации. Отравления ядами. Парами неметаллов и прочими соединениями.
- Ишемия. Как итог перенесенного инсульта, или течения энцефалопатии.
- Травмы.
- Особенности наследственности. Генетики пациента.
Выяснить причину можно достаточно быстро, чтобы начать лечение. Но устранить уже случившуюся дегенерацию не получится.
Причины глиоза
Глиоз не является самостоятельным заболеванием, это морфологическое проявление целого ряда патологий. Причинами, вызвавшими ускоренное размножение клеток нейроглии, могут стать:
Генетически обусловленные заболевания
- лизосомная болезнь накопления (болезнь Тея Сакса), характеризующаяся гибелью большого количества нейронов у детей с полугодичного возраста;
- туберозный склероз, проявляющийся образованием множественных доброкачественных опухолей в различных органах;
- рассеянный склероз –демиелинизация (разрушение покрывающей миелиновой оболочки) нервных волокон различных отделов ЦНС.
Врожденные и внутриутробные патологии
Причиной появления очагов глиоза в белом веществе головного мозга ребенка в этом случае являются:
- кислородное голодание (гипоксия) на протяжении внутриутробного развития или в родах;
- родовые травмы различной тяжести;
- увеличение содержания в крови углекислого газа (гиперкапния);
- перенесенные внутриутробно инфекционные заболевания.
Причины недуга
Даже самые обычные заболевания могут вызвать глиозные изменения головного мозга. Чем сильнее разрушение коснется нервных волокон, тем обширнее будет сформирован глиозный очаг.
Вызывают образование глиоза:
- Эписиндром.
- Гипертоническая болезнь.
- Рассеянный склероз.
- Сахарный диабет.
- Гипоксия.
- Нарушение кровообращения.
- Анемия.
- Энцефалопатия.
- Отек мозга.
Причины появления глиоза могут крыться и в:
- Наследственности.
- Родовых травмах.
- Преклонном возрасте.
- Чрезмерном потреблении легких углеводов и жирных продуктов.
Глиозные очаги могут быть единичными в случае отмирания нейронов, происходящего в процессе старения. В этом случае специалисты при помощи медикаментов стараются помочь пациенту не утратить жизненно важные функции нервной системы. Есть мнение, что именно глии, заполняющие межнейронные пространства и отвечающие за защитные, обменные и транспортные функции, в определенный момент начинают выделять вещество, уничтожающее нейроны. Такие изменения в организме и становятся главной причиной старения.
Кроме этого ученые считают, что глиоз может развиться в результате травмы мозга, чрезмерном употреблении больших доз алкоголя, приеме наркотиков, которые способствуют постепенному отмиранию нейронов.
Формы и степени развития
По морфологическим признакам:
- изоморфная форма глиоза – характеризуется упорядоченным разрастанием нейроглии;
- анизоморфный тип заболевания – отличается преобладанием клеточной структуры и хаотичным разрастанием;
- волокнистая форма – ярко выражены признаки преобладания волокнистой структуры.
По характеру процесса и его распространенности говорят об:
- Очаговом типе течения –ограниченный участок глиоза (чаще в теменной или височных долях), причиной возникновения которого послужили травма, инфекционный или воспалительный процесс.
- Диффузном типе течения –множественные поражения различного размера и локализации. Часто встречаются кистозно-глиозные образования сосудистого генеза.
В зависимости от расположения очагов глиоз подразделяется на:
- Перивентрикулярный глиоз – разрастания глии локализуются в области желудочков головного мозга.
- Периваскулярное расположение очагов (сосудистый глиоз) – наиболее распространенный тип течения. Отличается наличием разрастаний глии вдоль атеросклеротически пораженных сосудов. Диагностируется как микроангиопатия с наличием единичных или множественных очагов глиоза. Разновидность – субтенториальный тип (немногочисленные очаги появляются в результате родовых травм или возрастных изменений, а множественные возникают как следствие нарушения кровообращения).
- Субэпендимальный – единичные участки поражения, локализующиеся на внутренней оболочке желудочков.
- Маргинальный – очаги глиозного перерождения расположены в подоболочечной области.
- Краевой – участки заместительной глиальной ткани находятся на поверхности головного мозга.
Классификация
Подразделить патологический процесс можно по 4-м критериям. Первый и наименее понятный простому пациенту — это по структуре клеток, которые замещают нейроны.
По структуре клеток
Глия, как уже было сказано, очень неоднородна. Можно встретить разные типы клеток. Самые многочисленные — это так называемые астроциты. Название они получили за внешнее сходство со звездой.
Эти цитологические единицы различны по строению и, частично, по функциональным возможностям.
- Существуют волокнистые клетки. Которые имеют очень длинные отростки.
- Есть протоплазматическая разновидность. Крупные и «мясистые».
Соответственно, исходя из того, какие структуры в основном преобладают в пораженном участке, выделяют:
- Анизоморфный глиоз. Большая часть местных клеток — это протоплазматические астроциты. При этом разрастание тканей очень несистемное, хаотичное.
Нельзя выделить четкого паттерна распространения. Потому возможны рассеянные очаги глиоза. Это не хорошо, ведь будут вовлечены разные участки мозга.
А значит симптомы неврологического дефицита, нарушения будут более сложными и многогранными.
- Волокнистая форма. Встречается чаще. Рост имеет четкие границы и понятен с точки зрения распространения. Как и следует из названия, основу очага составляют такие астроциты. Клиническая картина касается, в основном, одной области. Разве что будет поражен огромный участок.
По количеству очагов
Второй критерий классификации — это количество очагов. Соответственно, выделяют:
- Диффузную форму. Как и следует из наименования, присутствует несколько точек поражения. Патологический процесс может затронуть как головной, так и спинной мозг. Часто, такое происходит на фоне воспалительного процесса, выраженного токсического поражения, ишемии. Нужно исследовать ситуацию, пациента в подробностях.
- Очаговая разновидность. Поражен один участок мозга. Например, часть какой-либо доли. Размеры могут быть разными. Суть в том, что клетки разрушены по одному периметру. На МРТ такие области выглядят как белые пятна. Изображения усиливаются после введение гадолиния.
Поскольку точка одна, симптомов меньше. Как правило. Существуют исключения. Очаг может быть огромен. Если она затрагивает сразу несколько областей церебральных структур, клиника будет соответствующей.
По локализации
Третье основание для классификации — это локализация патологического процесса.
- Субэпендимальное расположение. Очаг расположен в области желудочков нервных тканей.
- Краевая локализация. Изменения находятся под внешней оболочкой церебральных структур.
- Периваскулярное расположение. Обнаруживается вокруг измененного сосуда. Чаще всего патологический процесс развивается после перенесенного васкулита, иного поражения крупных магистральных артерий (или же мелких, бывает и такое, капиллярные сети тоже под прицелом).
Особняком стоят супратенториальные очаги глиоза, то есть расположенные возле мозжечка, патологический процесс развивается после ушибов, травм и дает выраженные нарушения работы экстрапирамидной системы: головокружения, расстройства координации, тошноту и прочие.
По степени тяжести
Наконец, подразделить состояние можно по общей тяжести патологического процесса. Это не общепринятый вариант, но он широко используется в той или иной вариации.
Всего можно назвать 4 формы нарушения по этому основанию:
- Нулевая. Начальный этап. Изменения минимальные, их почти нет. Потому и симптомы практически отсутствуют.
- Первая. Клиническая картина уже присутствует, но слабо выраженная. В виде единичных признаков патологического процесса.
- Вторая. Нарушения заметные. Расстройство сопровождается четкой группой симптомов очагового характера.
- Третья. Финальная степень. Из-за размеров измененной области или тяжести патологического процесса присутствует хорошо выраженная клиника. Плюс, неврологический дефицит, который инвалидизирует пациента. К счастью, вариант относительно редкий.
Очаги глиоза в головном мозге — это результат ишемии, дистрофии, механических повреждений, интоксикаций и прочих процессов.
Эти классификации не учитывают происхождение нарушения. Потому при выборе стратегии лечения нужно иметь в виду еще и этиологию проблемы.
По структуре самого очага
Есть и другие основания для классификации. Например, по структуре очага.
Выделяют:
- Кистозно-глиозные изменения головного мозга, которые сопровождаются как разрастанием глии, так и образованием мешочков, заполненных жидкостью.
- Солидные области. Гомогенные по структуре, состоят только из здоровых тканей.
Все классификации используются для более точного описания проблемы.
Очаги глиоза
Участки разрастания нейроглии представляют собой своеобразные шрамы на месте погибших нейронов, они могут быть единичными, включать до 3 глиозных очагов (немногочисленные поражения) или множественными. Величину разрастаний можно рассчитать по формуле: количество функционирующих нейроцитов к количеству клеток глии / в единице объема ткани. В норме этот показатель не превышает 1:8/10.
При повышении количества глиоцитов функционирование ЦНС нарушается вплоть до судорожного синдрома. Неврологи считают, что такое нарушение работы ЦНС чаще вызвано субтенториальными очагами глиоза сосудистого генеза или подкорковыми (субкортикальными) очагами.
Единичные очаги
Очаги глиоза небольшого размера не вызывают симптоматических проявлений.
У ребенка они образуются в результате полученной в процессе родов травмы, при этом может пострадать ткань любой доли головного мозга.
Но чаще единичные участки глиальных изменений локализуются в левой или правой теменной доле.
У взрослых причиной развития единичных очагов глиоза являются возрастные изменения или заболевания ЦНС. Такие участки практически не изменяются со временем, поэтому, в большинстве случаев, их невозможно выявить без специальных обследований.
Множественные очаги
Множественные очаговые изменения тканей мозга, как правило, развиваются в результате острого или хронического нарушения кровообращения. Формирующиеся очаги глиоза усиливают клиническую картину заболевания, которое явилось причиной их возникновения.
Множественные очаги субтенториального глиоза головного мозга появляются в результате черепно-мозговых травм и кровоизлияний в ткани под палаткой мозжечка. Эта зона уязвима за счет окружающих ее несжимаемых пространств, заполненных спинномозговой жидкостью.
Множественные очаговые изменения вещества мозга дистрофического характера развиваются при недостаточном кровоснабжении, хронических заболеваниях ЦНС, а также в результате возрастных изменений.
Лечение глиоза
Не существует специальных лекарств, вакцин, диет или каких-либо других методов, обеспечивающих успешное лечение глиоза головного мозга. Клетки нейроглии появляются вследствие развития другого заболевания, поражающего мозг. Поэтому важно найти его и устранить.
Если основной причиной гибели нервной ткани является процесс старения, то необходимо выполнить ряд профилактических мероприятий, тормозящих дальнейшее развитие глиоза головного мозга. Из медикаментов используют:
- Лекарства, улучшающие работу мозга.
- Средства, нормализующие процесс кровообращения.
- Витамины группы B.
При гипертонии назначаются лекарства, снижающие кровяное давление.
К какому врачу обратиться
При подозрении на наличие глиоза необходимо обратиться к неврологу. После проведенных исследований для подтверждения диагноза и определения тактики лечения могут потребоваться консультации у специалистов:
- кардиолога – при подозрении на глиоз сосудистого генеза;
- терапевта или семейного врача – для определения хронических болезней;
- эндокринолога – при сахарном диабете;
- нейрохирурга – при необходимости оперативного лечения.
У детей заподозрить развитие глиальных изменений на протяжении первого месяца после рождения может неонатолог. Позже изменения в развитии выявляет педиатр, который направит ребенка на консультацию детского невролога.
Традиционная медицина
Человек может жить, долго не предполагая, что у него развивается такое заболевание. Однако пускать на самотек развитие глиозных образований опасно. С тяжелыми степенями болезни справиться сложно. Нет лекарства, убирающего скопление нейроглий. Лечится глиоз с основой на коррекции основной патологии, такое ведение пациента покажет врачу эффективность его действий.
Чтобы улучшить состояние человека, традиционная медицина идет в трех направлениях:
- Профилактическое.
- Медикаментозное.
- Хирургическое лечение.
Профилактическое
Взрослый организм на ранней степени патологии сам борется с патологическими изменениями. Надо следовать врачебным рекомендациям.
Медикаментозное
Лечащий врач назначит лекарства против заболевания, провоцирующего рост глиозных тканей. Это средства, направленные на укрепление стенок артерий, препараты, повышающие активность мозговой деятельности. Лекарства для улучшения проводимости по нервным волокнам. Сосудистая этиология глиоза требует приема лекарств, улучшающих эластичность сосудистых стенок.
Препараты, применяемые при медикаментозном лечении:
- улучшают кровообращение, питают ткани мозга – Актовегин, Винпоцетин, Кавинтон, Циннаризин;
- предотвращают агрегацию тромбоцитов, укрепляют артериальные стенки – комплексы витаминов, лекарства с аспирином;
- повышают устойчивость нервов к стороннему воздействию ноотропы – Пирацетам, Фезам;
- препараты гиполипидемического действия – это статины, фибраты, они останавливают рост глиозной ткани; анальгетики – снимать боли в голове.
Хирургическое лечение
Применяется в исключительных случаях. Показаниями для нейрохирургического вмешательства являются судорожные и эпилептические приступы, серьезные нарушения работы внутренних органов, зависящих от нервной проводимости. Оперативным путем удаляются новообразования, лишний ликвор, образованные глиальными нарушениями. По ходу операции нейрохирург определяет необходимость шунтирования сосудов.
Внимание! Наличие множественных очагов является противопоказанием к хирургическому вмешательству, такие пациенты пожизненно принимают назначенные врачами медикаменты.
Диагностика
Выявить кистозно-глиозные изменения в тканях головного мозга можно только при проведении специальных исследований. К методам инструментальной диагностики глиоза относятся:
- ЭЭГ – тяжелый глиоз может спровоцировать появление эпилептических приступов. Поэтому при наличии изменений активности мозга проводят электроэнцефалограмму.
- Компьютерная томография с контрастированием – при помощи ангиографии определяют отклонения в функционировании и строении церебральных сосудов.
- Магнитно-резонансная томография – наиболее точный метод диагностики различных типов заболевания. Благодаря результатам МРТ можно определить наличие очагов демиелинизации, объем, расположение и причину возникновения глиального изменения.
- Для определения глиоза у плода на сроке до 20 недель проводится амниоцентез.
Определение патологии
Органические поражения ткани головного мозга часто сопровождаются кистозными изменениями. Патологические процессы, происходящие в мозговой ткани, влекут изменение ее структуры. Трансформация строения проявляется уменьшением количества волокон, повреждением миелина, изменением объема межклеточного пространства, замещением нейронов клетками глии.
Кистозно-глиозная трансформация, происходящая в головном мозге – это такой процесс, в ходе которого происходит разрастание нейроглии, что обычно связано с повреждением и гибелью нейронов. Механизм компенсаторного замещения поврежденной нервной ткани – защитная реакция организма, который пытается восстановить утраченные участки мозгового вещества и их функции.
Кистозно-глиозные разрастания также играют роль защитного барьера, который отграничивает здоровую ткань от патологического очага – опухоли, абсцесса, некроза. Образование кистозных участков препятствует нормальному кровотоку, что может провоцировать ишемические и атрофические процессы в близлежащих тканях.
Лечение
Специфической терапии глиоза не существует. Методы лечения зависят от основного заболевания, вызвавшего гибель нейронов. Основные цели терапии:
- замедлить прогрессирование процесса;
- обеспечить нормальную трофику тканей ЦНС;
- ликвидировать кислородное голодание;
- нормализировать процессы обмена веществ.
Традиционная медицина
Для устранения симптомов мозговых изменений назначаются следующие группы препаратов:
- Вазоактивные – лекарственные средства, активизирующие клеточный метаболизм и улучшающие трофику тканей (Кавинтон, Винпоцетин).
- Антиагреганты – препараты, замедляющие оседание тромбоцитов (все производные ацетилсалициловой кислоты).
- Средства, улучшающие состояние стенок мелких и крупных артерий (Аскорутин, витамины).
- Ноотропные вещества – они повышают устойчивость центральной нервной системы к воздействию негативных факторов (Пирацетам, Ноотропил).
- Статины – обладают гиполипидемическим свойством, препятствуя развитию атеросклероза (Фенофибрат, Аторвастатин).
- Обезболивающие и спазмолитики для купирования приступов головной боли.
Хирургия
Оперативное вмешательство при глиозе назначается крайне редко. Только при единичных очагах больших размеров.
После операции лечение базового заболевания, вызвавшего гибель нейронов необходимо продолжать, чтобы избежать развития рецидивов.
Показаниями к хирургическому вмешательству при крупном единичном очаге являются:
- нарушение оттока жидкости (ликвора);
- судорожные приступы, причиной которых является большой участок глиоза;
- диагностированное новообразование;
- изменение функционирования внутренних органов.
При мультиочаговом глиозе положительный эффект дает только постоянное консервативное лечение.
Дополнительные и альтернативные методы в домашних условиях
Методы народной медицины можно использовать только после консультации с врачом-неврологом. Гомеопатические средства назначаются как сопутствующие на фоне консервативной терапии.
Отвары и настои лекарственных растений и плодов улучшают функционирование сердечно-сосудистой системы и стимулируют обмен веществ.
Диета при глиозных изменениях
Диета при глиозе направлена на:
- Улучшение функционирования головного мозга и снятие сосудистых спазмов. Для достижения этого результата необходимо употреблять в пищу продукты богатые магнием: гречневая, перловая, кукурузная крупы, орехи, тыквенные семечки, чечевица, капуста всех сортов, инжир.
- Купирование отеков, улучшение работы сердца – в рацион вводятся продукты с повышенным содержанием калия: цитрусовые, овощи и фрукты зеленого цвета, сухофрукты, блюда из грибов и картофеля.
- Снижение веса – для контроля массы тела из ежедневного питания убирают сдобу, консервы, газированные сладкие напитки, копчености, жирное мясо, фастфуд и полуфабрикаты.
Ежедневный рацион формируют из рыбы, нежирного мяса, каш, кисломолочной продукции, твердого сыра, овощей, орехов и фруктов. Лучше готовить на пару, отваривать или запекать продукты.
Методы лечения
Лечение глиоза направлено на устранение причин патологии – в первую очередь проводится терапия первичного заболевания, поразившего структуры головного мозга. Специфического лечения глиозных изменений не предусмотрено. В зависимости от показаний назначают лекарственные препараты, реже проводят операцию.
Диета предполагает сокращение в рационе количества животных жиров, соли, рафинированных сладостей. В числе продуктов, питающих нервные клетки, стоит отметить семечки, орехи, морскую и речную рыбу, овощи, фрукты. Питание при глиозе головного мозга должно быть полноценным и сбалансированным.
Важно, чтобы в рационе присутствовали продукты, богатые полиненасыщенными жирными кислотами, растительной клетчаткой, витаминами, особенно группы B, микроэлементами. Множественные очаги глиоза, обнаруженные в ходе исследования структур головного мозга, независимо от размера требуют динамического наблюдения. Периодичность контрольных исследований назначает лечащий врач.
Медикаментозная терапия
Как лечить глиоз головного мозга расскажет лечащий врач, опираясь на результаты диагностического обследования с учетом первичной патологии, возраста пациента и симптоматики. Основные лекарственные средства:
- Ноотропные. Защищают нейроны от повреждений, стимулируют обменные процессы в нервных клетках.
- Регулирующие мозговой кровоток. Препараты, нормализующие деятельность кровеносной системы, питающей мозг.
- Антиоксидантные. Препараты, препятствующие окислительным реакциям в нервной ткани.
- Антигипертензивные. Лекарства, нормализующие показатели артериального давления.
Параллельно в зависимости от вида первичного заболевания и симптомов назначают препараты для устранения неврологической симптоматики. Эта группа включает противосудорожные, противоэпилептические, обезболивающие, противорвотные лекарства.
Хирургическое вмешательство
К оперативному лечению прибегают, когда невозможно поддерживать хорошее самочувствие пациента медикаментозными средствами. Хирургическое лечение глиоза показано при определенных условиях:
- Единичные, крупные очаги.
- Наличие выраженной неврологической симптоматики – судорожный синдром, эпилептические припадки, серьезные нарушения двигательной активности и умственной деятельности.
- Возраст пациента не старше 60 лет.
- Масс-эффект (негативное влияние образования на окружающие здоровые структуры мозга).
В ходе операции удаляют участки кистозно-глиозной ткани, которые провоцируют симптомы и расстройства. Лечение должно проводиться комплексно и быть своевременным.
Народные средства
Лечение глиоза, поразившего головной мозг, народными средствами малоэффективно. Народные методы включают прием отваров, настоев, настоек, приготовленных из лекарственных растений, обладающих антигипертензивными, противовоспалительными свойствами. Показаны домашние препараты, улучшающие кровоснабжение отделов мозга, приготовленные на основе болиголова, клевера, диоскореи.
В числе полезных лекарственных растений, которые устраняют воспалительные процессы, укрепляют иммунитет, улучшают обмен веществ, стоит отметить черный тмин, заячью капусту, манжетку, мордовник шароголовый, тысячелистник, пырей, мыльнянку. Народные целители рекомендуют настойку, приготовленную из корня валерианы, травы мяты, пиона и пустырника, ягод боярышника, в качестве общеукрепляющего, успокаивающего, иммуностимулирующего средства.
Осложнения и последствия
Наличие обширных областей замещения нейронов глиоцитами грозят опасными последствиями:
- постоянные, не купируемые лекарственными препаратами головные боли;
- расстройства умственной деятельности;
- необратимая потеря речи, зрения или слуха;
- судороги и эпилептические приступы;
- паралич (частичный или полный);
- психические расстройства;
- нарушение координации движений;
В крайне редких случаях глиоз не генетического генеза становится причиной летального исхода.
Виды
В месте некроза начинает освобождаться место для разрастания нейроглии, образующей островки глиоза.
Виды глиоза зависят от его формы, характера и локализации распространения:
- Сосудистый глиоз, который так же называют периваскулярным – наиболее часто встречающийся вид глиоза. При этом виде глия разрастается вокруг сосудов, которые поражены атеросклерозом. Он имеет подвид – супратенториальный глиоз.
- Маргинальный вариант глиоза – глиоз, с четким расположением в подоболочечной области.
- Анизоморфная разновидность – очаги глиоза располагаются хаотично (в отличие от предыдущего вида).
- Изоморфный тип — при данном типе расположение волокон глии имеет определенную правильную последовательность.
- Субэпиндимальная форма — единичные островки глиоза, появляющиеся со стороны внутренней поверхности желудочков.
- Краевое поражение – островки глии разрастаются в наружной части мозга.
- Диффузный глиоз – множественное поражение ЦНС.
- Волокнистый глиоз – островки глиоза в виде волокон.
Очаги глиоза по своему количеству разделяются на: единичные, немногочисленные (не больше 3-х) и множественные.
Среди причин единичного очага выделяют травму при родах или пожилой возраст пациента (в данном случае процесс считается естественным)
Единичные островки обычно не разрастаются, из-за чего они часто являются случайной находкой при диагностике с помощью высокоточной аппаратуры.
Многочисленные очаги глиоза часто являются следствием острого (инсульты) или хронического (атеросклеротическое поражение, сдавливание сосудов, атрофия тканей ЦНС) нарушений мозгового кровообращения. Так образуется сосудистый глиоз, усугубляющий клиническую картину основных заболеваний (нарушается внимание, появляется головокружение, начинает болеть голова, возникают скачки давления и др.). Следовательно, причиной периваскулярного глиоза являются ОНМК и ХНМК, у которых в свою очередь так же есть причины появления.
Отдельным видом сосудистого глиоза является супратенториальный глиоз – разрастание нейроглии около сосудов, пораженных атеросклерозом. Он располагается под палаткой мозжечка – отростком Dura mater, находящимся между мозжечком и затылочной долей. Такое расположение и нахождение вокруг несжимаемых пространств с ликвором определяет уязвимость затылочной доли как при черепно-мозговых травмах и травмах в родах, так и относительно разрастания сосудистого глиоза.
Единичные островки глиоза часто протекают бессимптомно и обнаруживаются случайно во время диагностики (МРТ, ангиография), но при развитии глиоза (разрастание клеток глии, возникновение новых очагов, атрофия тканей мозга) он начинает проявляться клинически.
Существуют следующие симптомы глиоза головного мозга, которые нельзя оставлять без внимания:
- Нестерпимая постоянная головная боль. При этом спазмолитики не приносят облегчение.
- Перепады и эпизоды падения АД.
- Частые головокружения, падение работоспособности.
- Снижение слуха и зрения.
- Ухудшение внимания и памяти.
- Нарушение движения.
Стоит сказать, что симптомы и признаки глиоза сильно зависят от местонахождения поражения:
Поражение глиозом лобных долей часто возникает в пожилом возрасте, т.к. является следствием старения организма. В данном случае глиоз является первичным заболеванием, если не было факторов, способных его спровоцировать. Именно глиозом можно объяснить снижение памяти, неточные движения и замедленные реакции у пожилых людей.
Посттравматическое глиозное поражение вызывает очень интенсивную часто возникающую головную боль. Такая боль в сочетании со скачками давления может возникнуть и при глиозе сосудистого происхождения.
Возникновение эпилептических припадков и повышение судорожной готовности мозга могут возникать при грозном поражении глиозом белой субстанции головного мозга. Вследствие ЧМТ и хирургических вмешательств часто могут возникать головокружения и судорожные припадки.
Супратенториальный глиоз вызывает нарушения зрения (невозможность распознавания предметов, выпадение участков полей зрения, контуры и размеры предметов искажаются, возникают зрительные галлюцинации).
Профилактика
Для того чтобы предотвратить распространение очагов, необходимо придерживаться нескольких простых правил:
- вести здоровый образ жизни с посильной физической активностью;
- придерживаться выбранной диетологом диеты;
- отказаться от вредных привычек;
- соблюдать режим труда и отдыха;
- выполнять все назначения лечащего врача.
Замена погибших нейронов глиоцитами физиологический компенсаторный процесс, обеспечивающий функциональность мозга при некритических повреждениях. Однако, появление участков глиоза говорит о наличии других заболеваний, угрожающих здоровью центральной нервной системы, лечить которые необходимо своевременно и в полном объеме.
Этиология заболевания
Глиоз – накопление глиальных клеток в некоторых частях центральной нервной системы или глаза. Пролиферация глиальных клеток наблюдается в областях, которые были повреждены болезнью или травмой.
Эпиретинальный глиоз принимает здесь особую форму: в пограничной зоне между сетчаткой и стекловидным телом накапливаются коллагеновые клетки. Большинство из них происходят из клеток Мюллера в сетчатке. Из-за своего анатомического положения эпиретинальный глиоз – единственная видимая форма болезни.
Глиальные клетки составляют ненейрональный компонент ЦНС, превосходя по численности нейроны. По анатомической классификации проводится дифференциация на две основные группы: макроглиоз и микроглиоз.
Астроциты – глиальные клетки, которые в основном отвечают за реакцию тканей на повреждение. Макроглиоз включает пролиферацию и гипертрофию астроцитов через сложные молекулярные и клеточные пути.
Как выглядит глиоз головного мозга
Микроглиоз в основном возникает, если инсульт вызван инфекционным заболеванием – энцефалитом, к примеру. Микроглиальные клетки, которые не имеют нейроэпителиального происхождения, вероятно, происходят из предшественников моноцитов или макрофагов.
Народная медицина
На ранней степени развития глиоза можно применять народные средства. Здесь используются сборы трав, активизирующие обращение крови, функции мозга, что одновременно с приемом лекарств народные средства оказывают дополнительную поддержку организма для улучшения самочувствия человека.
Начальная степень глиоза с небольшими очагами поражения требует приема трав, стабилизирующих обменные процессы и снабжение кровью тканей мозга. Если человек вдобавок страдает от ожирения, надо проводить дни голодания, разгрузки. Они очищают организм от вредных веществ, приводящих к дисфункциям.
Важно! Длительного эффекта от приема лекарств и народных средств не будет, если не устраняются причины глиоза.
Для торможения склероза:
- Настойка на кагоре. Способ применения: 400 г измельченных листьев алоэ 5-летнего возраста смешиваются с 650 мг меда и 650 г красного кагора. Настаивается в темноте 5 суток. Способ применения: пить по 1 ч. л. 3 раза в день перед приемом пищи. Курс – 2–4 недели.
- Настой семян укропа с валерианой. Способ приготовления: 2 ст. л. семян укропа смешиваются со стаканом измельченного корня валерианы, заливается 1 л кипятка. Настаивается сутки, процеживается. Добавляется 1,5-2 стакана меда. Способ применения: пить до еды по 1 ст. л. 4–6 недель.
- Настой боярышника. Ягоды боярышника высыпаются в термос 1 л, 15-20 плодов; заливаются кипятком. Настаиваются ночь, процеживаются. Способ применения: настой пить по 1 ст. л. за ½ часа до еды, 1,5 месяца.
Средства можно делать из клевера, травы болиголова. Или приобретать готовые аптечные сборы. Лекарственные растения не избавят от патологии, но смягчат ее проявления.
Причины возникновения.
К числу провоцирующих факторов относят:
- Болезни головного мозга инфекционной природы.
- ЧМТ.
- Хирургические вмешательства.
- Воспаления в головном мозге.
- Сосудистые нарушения, сопровождающиеся ухудшением кровообращения.
- Инсульты и инфаркты.
- Алкоголизм хронической формы.
- Заболевания, приводящие к атрофическим изменениям (напр., рассеянный склероз).
- Наследственность – отклонения в обмене липидов чревато нарушениями работы ЦНС.
Бывают случаи внутриутробного развития патологии.